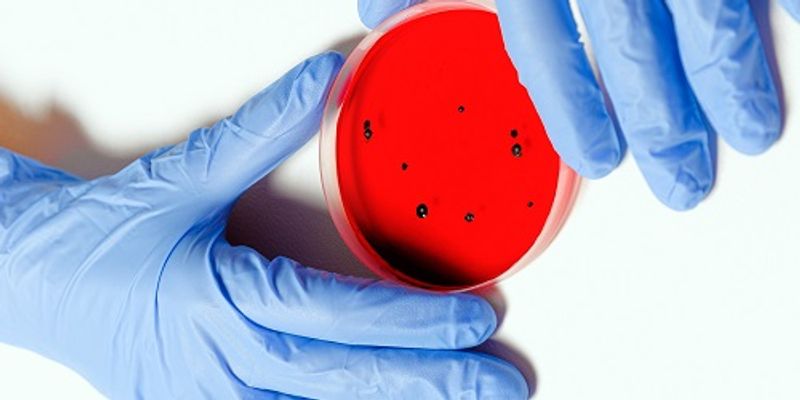

Microbiology and Immunology
Both being a branch of biology, microbiology is the research of the smallest living things including bacteria, fungi, algae, protozoa, and viruses, and immunology includes studies relating to organism immune systems and organism responses to foreign substances, which includes microbes.
What's Popular in Microbiology and Immunology
-
MAY 12, 2025Cell & Molecular BiologyThe immune system can work in two ways: the innate immune system reacts to any foreign invaders that are identified by i ...Written By: Carmen LeitchAPR 24, 2025ImmunologyMany different cancer treatments work to directly target the tumor or the cells around it. The immediate goal is to miti ...Written By: Brian G. MorrealeSEP 12, 2024ImmunologyInflammation is the body’s natural response to injury and infections. It promotes healing through immune cel ...Written By: Brian G. MorrealeMAR 06, 2024Clinical & Molecular DXMany of us wanted to get a COVID-19 vaccine as soon as it was available, but someone took that to a wild extreme.Written By: Carmen LeitchMAR 04, 2024Clinical & Molecular DXUrinary tract infections (UTIs) arise when bacteria infects that part of the body, usually by moving through the urethra ...Written By: Carmen Leitch
MAY 12, 2025
Cell & Molecular Biology
The immune system can work in two ways: the innate immune system reacts to any foreign invaders that are identified by i
...
Written By:
Carmen Leitch
APR 24, 2025
Immunology
Many different cancer treatments work to directly target the tumor or the cells around it. The immediate goal is to miti
...
Written By:
Brian G. Morreale
SEP 12, 2024
Immunology
Inflammation is the body’s natural response to injury and infections. It promotes healing through immune cel
...
Written By:
Brian G. Morreale
MAR 06, 2024
Clinical & Molecular DX
Many of us wanted to get a COVID-19 vaccine as soon as it was available, but someone took that to a wild extreme.
Written By:
Carmen Leitch
MAR 04, 2024
Clinical & Molecular DX
Urinary tract infections (UTIs) arise when bacteria infects that part of the body, usually by moving through the urethra
...
Written By:
Carmen Leitch
FEB 22, 2024
Microbiology
Dr. Nicole Foley of Texas A&M and colleagues studied myotis bats to learn more about how their 'nightclubs' promote immu
...
Written By:
Carmen Leitch
FEB 08, 2024
Microbiology
Climate change is raising temperatures around the world, and mosquitoes are on the move. As their territories expand, th
...
Written By:
Carmen Leitch
FEB 05, 2024
Immunology
Introduction Proteins are essential molecules in the human body that construct the building blocks of life. Long chains
...
Sponsored By:
MilliporeSigma
JAN 31, 2024
Microbiology
Measles is probably humanity's most infectious disease; an estimated 9 of 10 unvaccinated, exposed people are infected w
...
Written By:
Carmen Leitch
-
MAR 20, 2024 | 8:00 AMLuminex and Thermo Fisher Scientific are excited to feature two presentations highlighting the advanced features of the Invitrogen™ Luminex® xMAP® INTELLIFLEX™ DR-SE inst...Speaker: Sherry Dunbar, Ph.D., MBA , Sigrun Badrnya, Ph.D.Sponsored By: Thermo Fisher ScientificDEC 07, 2023 | 11:00 AMAbstract text Learning Objectives Webinars will be available for unlimited viewing after live event....OCT 18, 2023 | 9:00 AMIn this webinar, Jenny Meredith, Ph.D., HCLD(ABB), Clinical Microbiology Director at Prisma Health-Upstate joins forces with Sara Ezra, Molecular Supervisor at Pathology Consultants (subsidi...SEP 26, 2023 | 9:00 AMAlamar NULISAseq is a novel commercial platform for highly multiplexed analysis of soluble proteins using a modified proximity ligation assay. We compared Luminex, Olink, and NULISAseq platf...Cell-based immunotherapy has become the new-generation cancer medicine, and “off-the-shelf” cell products that can be manufactured at large scale and distributed readily to treat...
MAR 20, 2024 | 8:00 AM
Luminex and Thermo Fisher Scientific are excited to feature two presentations highlighting the advanced features of the Invitrogen™ Luminex® xMAP® INTELLIFLEX™ DR-SE inst...
Speaker:
Sherry Dunbar, Ph.D., MBA
, Sigrun Badrnya, Ph.D.
Sponsored By: Thermo Fisher Scientific
DEC 07, 2023 | 11:00 AM
Abstract text Learning Objectives Webinars will be available for unlimited viewing after live event....
OCT 18, 2023 | 9:00 AM
In this webinar, Jenny Meredith, Ph.D., HCLD(ABB), Clinical Microbiology Director at Prisma Health-Upstate joins forces with Sara Ezra, Molecular Supervisor at Pathology Consultants (subsidi...
SEP 26, 2023 | 9:00 AM
Alamar NULISAseq is a novel commercial platform for highly multiplexed analysis of soluble proteins using a modified proximity ligation assay. We compared Luminex, Olink, and NULISAseq platf...
Cell-based immunotherapy has become the new-generation cancer medicine, and “off-the-shelf” cell products that can be manufactured at large scale and distributed readily to treat...
JUL 20, 2023 | 8:00 AM
Single-cell ATAC-seq (Assay for Transposase-Accessible Chromatin using sequencing, scATAC-seq) is a relatively new and powerful technique that allows researchers to identify open chromatin r...
JUN 08, 2023 | 9:00 AM
In the emergency department, distinguishing between bacterial and viral infections can be challenging, leading to inappropriate use of antibiotics that may contribute to the development of b...
MAY 17, 2023 | 10:00 AM
Participate in this educational webinar to learn about key objects in Treponemal screening. Today's presentation will cover the following topics from the perspective of a NYC based Labor...
APR 20, 2023 | 11:00 AM
Date: April 20, 2023 Time: 11:00am (PDT), 2:00pm (EDT), 8:00pm (CEST) Multiplexed antibody-based imaging enables the characterization of cellular interactions, spatial relationships, and his...
-
Labroots is excited to bring academia and industry, research experts, virologists, microbiologists, healthcare professionals, and leading biomedical scientists under one roof at our 12 th An...Labroots is excited to announce the 17th Annual Event in the Clinical Diagnostics & Research Virtual Event Series taking place on November 11th, 2026! This event will again bring togethe...Labroots is pleased to announce the 6 th annual event in the Immuno-Oncology Virtual Event Series taking place on April 28th, 2027. Immuno-Oncology is at the forefront of groundbreaking rese...Labroots is excited to bring academia and industry, research experts, virologists, microbiologists, healthcare professionals, and leading biomedical scientists under one roof at our 13 th An...Labroots is excited to announce the 18th Annual Event in the Clinical Diagnostics & Research Virtual Event Series taking place on November 10th, 2027! This event will again bring togethe...
Labroots is excited to bring academia and industry, research experts, virologists, microbiologists, healthcare professionals, and leading biomedical scientists under one roof at our 12 th An...
Labroots is excited to announce the 17th Annual Event in the Clinical Diagnostics & Research Virtual Event Series taking place on November 11th, 2026! This event will again bring togethe...
Labroots is pleased to announce the 6 th annual event in the Immuno-Oncology Virtual Event Series taking place on April 28th, 2027. Immuno-Oncology is at the forefront of groundbreaking rese...
Labroots is excited to bring academia and industry, research experts, virologists, microbiologists, healthcare professionals, and leading biomedical scientists under one roof at our 13 th An...
Labroots is excited to announce the 18th Annual Event in the Clinical Diagnostics & Research Virtual Event Series taking place on November 10th, 2027! This event will again bring togethe...
NOV 12, 2025
| 5:30 AM PST
C.E. CREDITS
Labroots is excited to announce the 16th Annual Event in the Clinical Diagnostics & Research Virtual Event Series taking place on November 12th, 2025! This event will again bring togethe...
SEP 03, 2025
| 5:30 AM PDT
C.E. CREDITS
Labroots is excited to bring academia and industry, research experts, virologists, microbiologists, healthcare professionals, and leading biomedical scientists under one roof at our 11 th An...
NOV 13, 2024
| 6:00 AM PST
C.E. CREDITS
Labroots is excited to announce the 15th Annual Event in the Clinical Diagnostics & Research Virtual Event Series! This event will again bring together clinicians, researchers, medical e...
SEP 03, 2024
| 6:00 AM PDT
C.E. CREDITS
Labroots is excited to bring academia and industry, research experts, virologists, microbiologists, healthcare professionals, and leading biomedical scientists under one roof at our 10 th An...